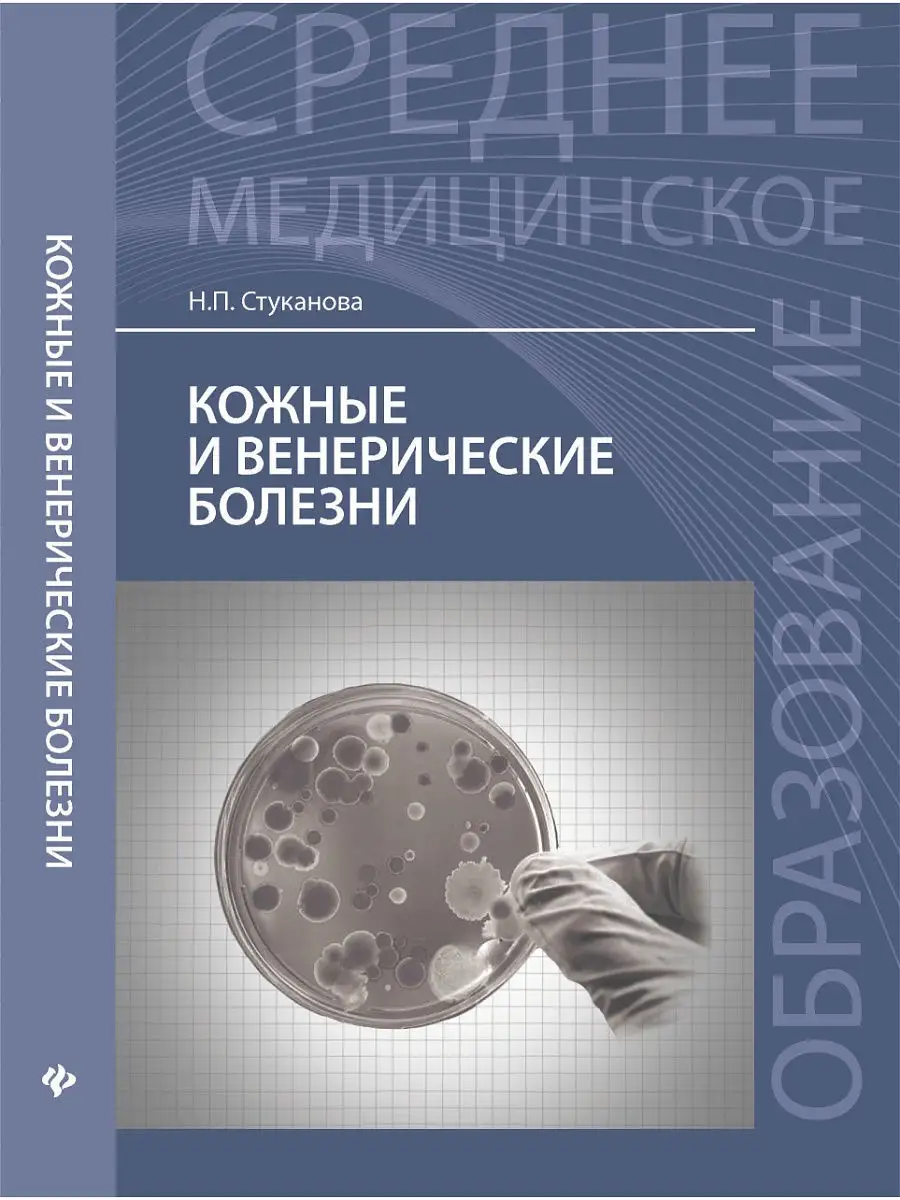

Бутов дерматовенерология
Поздравление с днем учителя маленькие стихи
Куда бить данные
Как покрасить кирпич на стене
Амбушюрные наушники
Стать близоруким
Samsung tab active t365
Уходящая луна в октябре 2025
Мазь от баланита
Прическа со сбритым
Микатсу 15 2х тактный
2 решите уравнение 42 x 33
А вот так возможно
Генерала посадили в тюрьму
Бутов дерматовенерология 162 фото